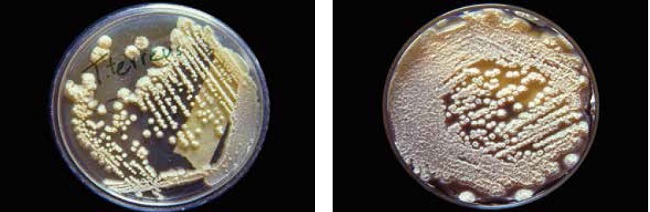
Figura 3

Aportación original
Frecuencia de micosis invasivas en un hospital mexicano de alta especialidad. Experiencia de 21 años
Frequency of invasive fungal infections in a Mexican High-Specialty Hospital. Experience of 21 years
Frecuencia de micosis invasivas en un hospital mexicano de alta especialidad. Experiencia de 21 años
Revista Médica del Instituto Mexicano del Seguro Social, vol. 54, núm. 5, pp. 581-587, 2016
Instituto Mexicano del Seguro Social
Recepción: 27 Agosto 2015
Aprobación: 18 Febrero 2016
Resumen:
Introducción: Factores como el cáncer, la infección por VIH, así como el uso de esteroides y antibióticos, incrementan el número de micosis invasivas (MI).
Métodos: Para conocer la frecuencia y algunos aspectos epidemiológicos de las MI en un hospital del IMSS, se revisaron los casos probados diagnosticados en los últimos 21 años (1993-2013) en el Laboratorio de Micología Médica.
Resultados: Se identificaron 472 casos, distribuidos en: 261 candidosis, 82 mucormicosis, 60 criptococosis, 43 aspergilosis y 16 histoplasmosis. La candidosis disminuyó de 74 casos en los primeros 6 años, a 48 en los cinco últimos. La localización principal fue pulmonar y el principal agente fue C. albicans. La criptococosis también disminuyó de 24 a 10 casos, principalmente fue causada por C. neoformans, aunque hubo dos casos de C. laurentii, uno de C. terreus y uno de C. unigutulatus. La mucormicosis se mantuvo constante, pero la aspergilosis se incrementó pasando de 2 casos en el primer periodo a 23 en el último.
Conclusiones: Es importante que los hospitales de alta especialidad, cuenten con laboratorios de micología médica para realizar el diagnóstico de MI. Se sugiere crear un Centro Nacional de Referencia de Micosis donde se concentren los datos de estas infecciones y contribuya en la elaboración de planes de educación para la salud, prevención, diagnóstico y tratamiento de las mismas.
Palabras clave: Infecciones bacterianas y micosis, Micosis, Infección.
Abstract:
Background: Factors such as cancer, HIV infection, use of corticosteroids and antibiotics, favors the increase in the number of invasive fungal infections (IFI) worldwide.
Methods: To determine the frequency and epidemiological aspects of IFI at a mexican, a review of the proven cases diagnosed over the past 21 years (1993-2013) in the Laboratory of Medical Mycology was performed.
Results: A total of 472 cases were identified as: 261 candidiasis, 82 mucormycosis, 60 cryptococcosis, 43 aspergillosis and 16 histoplasmosis. A decrease in the frequency of candidiasis was observed, with 74 cases in the first 6 years and 48 in the last five. C. albicans was the most common agent and pulmonary infection the most prevalent. Cryptococcosis also declined from 24 to 10 cases, mainly caused by C. neoformans; two cases of C. laurentii and C. terreus and C unigutulatus were isolated once. Mucormycosis remained steady, but aspergillosis increased significantly, and from 2 cases found in the first studied period, it rose to 23 in the last one.
Conclusions: It is important that High Specialty Hospitals have well-equipped laboratories of Medical Mycology. We suggest the creation of a National Reference Center for Mycoses to collect all the data of these infections, in order to help to the development of strategies for health education, prevention, diagnosis and treatment of them.
Keywords: Bacterial infections and mycoses, Mycoses, Infection.
La definición de micosis invasivas (MI) fue desarrollada en 2002 a partir de los trabajos conjuntos entre el European Organization for Research and Treatment of Cancer/Invasive Fungal Infections Cooperative Group, el National Institute of Allergy and Infectious Diseases y el Mycoses Study Group (EORTC/MSG).1,2 El término engloba a las infecciones fúngicas causadas por hongos levaduriformes, filamentosos o dimórficos, que se diseminan por vía hematógena y afectan diversos órganos.3,4 Estas infecciones son graves y, en ocasiones, mortales. La fiebre es una de las principales manifestaciones clínicas.2,3,5 Su manejo óptimo depende de un diagnóstico clínico acertado, del aislamiento e identificación del agente causal, y de un tratamiento temprano, específico y oportuno. 6
De acuerdo con los criterios emitidos por la EORTC/MSG, publicados en 2008, las MI se clasifican en: probadas, probables y posibles.2 Las infecciones probadas requieren la demostración de elementos fúngicos en los tejidos infectados mediante: análisis microscópico (histopatología, citopatología o examen directo), cultivo del agente etiológico o por pruebas inmunológicas de alta especificidad y sensibilidad. Las infecciones probables requieren que el hospedero presente uno o varios de los factores predisponentes asociados con mayor frecuencia (neutropenia, receptores de trasplantes, uso prolongado de corticosteroides u otras terapias inmunosupresoras e inmunodeficiencias hereditarias, datos clínicos sugestivos de infección micótica y evidencia micológica). Por último, se considera como infección posible a aquellos casos que cuenten con factores de riesgo del hospedero y evidencia clínica suficiente y consistente con MI, aún sin evidencia micológica.2
Las MI, también pueden ser agrupadas en dos categorías clínico-micológicas: las oportunistas y las endémicas. Los agentes más frecuentes de micosis oportunistas son Candida spp., Cryptococcus neoformans, Pneumocystis jirovecii, Aspergillus spp. y hongos del orden Mucorales. Los principales agentes de las micosis invasivas endémicas de América del Norte son Histoplasma capsulatum, Coccidioides immitis, C. posadasii y Blastomyces dermatitidis.3,4
Los factores de riesgo para desarrollar MI son neutropenia, trasplante de médula ósea o de órganos sólidos, neoplasias hematológicas, el uso prolongado de altas dosis de corticosteroides, quimioterapia, infección por VIH, tratamiento con nuevos agentes inmunosupresores, desnutrición, estancia prolongada en unidades de cuidados intensivos, cirugías mayores, edad avanzada y comorbilidades como diabetes mellitus asociada a cetoacidosis, cirrosis y permaturez.3,4,6 En el caso de la aspergilosis, el número de casos de infección invasiva incrementa su frecuencia cuando se realizan remodelaciones en los hospitales o en las proximidades del mismo, debido al aumento en el número de partículas fúngicas suspendidas.4
En los hospitales de alta especialidad que cuentan con servicios de Trasplantes, Hematología, Cuidados Intensivos, Diálisis Peritoneal, Reumatología, etc., la frecuencia de estas infecciones ha tenido un aumento constante debido a que los pacientes presentan simultáneamente varios factores predisponentes.3,7 Los pacientes de estas unidades frecuentemente desarrollan fiebre de origen desconocido. En un estudio publicado en 2012, realizado en pacientes de este hospital con Síndrome Febril, el cual fue causado por infecciones fúngicas hasta en la tercera parte de los casos.7
La mortalidad en los pacientes con MI es elevada y se asocia al retraso en el diagnóstico, el tratamiento, o por la severidad de la enfermedad.5,8,9 En los últimos años se ha presentado un nuevo factor que incrementa la mortalidad: la falla terapéutica debida a la resistencia a los antimicóticos. La resistencia antifúngica de hongos patógenos u hongos contaminantes, puede desarrollarse secundariamente a la exposición repetida a compuestos antimicóticos como ha sido demostrado en diversas investigaciones sobre Candida, Cryptococcus y Aspergillus;4,10,11 sin embargo, algunas especies de hongos contaminantes como las del género Fusarium, presentan resistencia primaria a los antifúngicos.
El objetivo de este trabajo fue determinar la frecuencia de las principales MI en pacientes del Hospital de Especialidades, Centro Médico Nacional Siglo XXI del IMSS a lo largo de 21 años, así como conocer algunas de las características epidemiológicas de los casos y sus factores asociados.
Métodos
Se revisó el registro de las MI diagnosticadas en el Laboratorio de Micología Médica entre enero de 1993 y diciembre de 2013.
Se incluyeron únicamente los casos de MI probadas mediante: a) examen directo con KOH y frotis de especímenes teñidos con técnicas de Gram o Ziehl-Neelsen; b) cultivos en agar dextrosa Sabouraud con y sin antibióticos; c) observación de hongos en fragmentos de tejido teñidos con hematoxilina-eosina, ácido peryódico de Schiff o impregnación argéntica. En algunos casos los tejidos fueron macerados con solución salina isotónica para realizar examen directo, frotis y cultivo.
La identificación de los hongos filamentosos fue determinada por morfología macro y microscópica, y en algunos casos por microcultivos. La identificación de los hongos levaduriformes fue realizada por morfología macro y microscópica, prueba de filamentación en suero, cultivo en medio cromogénico (CHROMagar), ensayos bioquímicos con sistema automatizado (Vitek, Biomerieux) o con kits comerciales (API-20 AUX® y APIC-32, Biomerieux).
El desarrollo de esta investigación no incluyó la participación de sujetos humanos ni de animales de experimentación. La revisión de expedientes, resultados de laboratorio y reportes de estudios de biopsias, guardaron en todo momento la confidencialidad de los pacientes.
Resultados
Durante el periodo de 1993 a 2013 se diagnosticaron 472 MI, las más frecuentes fueron: candidosis, mucormicosis, criptococosis y aspergilosis (figura 1).

Micosis invasivas diagnosticadas en el periodode 1993-2013 en el Hospital de Especialidades del CentroMédico Nacional Siglo XXI
En el cuadro I se muestra el número de casos registrado en el periodo de estudio. Los casos de candidosis y criptococosis mostraron una disminución importante, pasando de 74 y 24 casos respectivamente entre los años de 1993-1998, a solo 48 candidosis y 10 criptococosis en el periodo 2009-2013. La mucormicosis se mantuvo en cifras similares, mientras que la aspergilosis se incrementó notablemente: en el periodo 1993-1998 se registraron 2 casos, y en el último fueron 23.
| Micosis | 1993-1998 | 1999-2003 | 2004-2008 | 2009-2013 | Total |
| Candidosis | 74 | 59 | 80 | 48 | 261 |
| Mucormicosis | 24 | 21 | 16 | 21 | 82 |
| Criptococosis | 24 | 15 | 11 | 10 | 60 |
| Aspergilosis | 2 | 8 | 10 | 23 | 43 |
| Histoplasmosis | 4 | 7 | 4 | 1 | 16 |
| Coccidioidomicosis | 0 | 0 | 3 | 1 | 4 |
| Neumocistosis | 0 | 0 | 2 | 1 | 3 |
| Scedosporiosis | 0 | 1 | 0 | 0 | 1 |
| Alternariosis | 0 | 1 | 1 | 0 | 2 |
| Total | 128 | 112 | 127 | 105 | 472 |
En el cuadro II se muestra la localización de los 261 casos de candidosis. Los principales sitios de infección fueron el pulmón y el peritoneo. Los productos biológicos con mayor positividad en infecciones por Candida fueron el líquido de lavado bronquio-alveolar (LBA), liquido de diálisis peritoneal y fragmentos de tejido. La mayoría de los pacientes tenía hemopatías graves (aplasia medular, leucemia) o trasplante de médula ósea. El agente causal más frecuente fue Candida albicans (164 casos, 63%); otras especies de menor frecuencia fueron C. tropicalis (21 casos, 7.9%), C. glabrata (18 pacientes, 7.1%), C. parapsilosis (10 casos, 3.9%), C. krusei (6 casos, 2.4%), C. famata (3 casos), C. lusitaniae y C. humícola dos casos cada una. En 35 pacientes solo se determinó el género del agente causal.
| Localización | Casos |
| Pulmonar | 184 |
| Peritoneal | 19 |
| Tejidos diversos de biopsias | 19 |
| Cara y cuello | 7 |
| Pierna | 5 |
| Candidemia | 5 |
| Sistema nervioso central | 5 |
| Vías biliares | 3 |
| Intestino | 3 |
| Páncreas | 3 |
| Hígado | 2 |
| Hueso | 2 |
| Pene | 1 |
| Nalga | 1 |
| Articular | 1 |
| Absceso esplénico | 1 |
La infección por hongos filamentosos más frecuente fue la mucormicosis (82 casos), de los cuales 79 (96.3%) fueron de localización rinocerebral y tres de localización pulmonar (figura 2). En 85.3% (70 casos) los pacientes tenían cetoacidosis diabética, ocho presentaban inmunosupresión por diversas causas (enfermedad renal, tratamiento con esteroides, enfermedades autoinmunes, etc.) y en cuatro casos el único factor identificado fue la edad avanzada (> 65 años). De los 82 pacientes, 37 (45.12%) fallecieron, y de los sobrevivientes, 40 (88.9%) tuvieron secuelas permanentes debidas a cirugías o debridación quirúrgica extensa. El examen directo y el cultivo fueron positivos en 42 pacientes (51.2%); en los 40 pacientes restantes el diagnóstico se estableció por estudio histológico y/o examen directo. En los cultivos, el género identificado con mayor frecuencia fue Rhizopus sp. (26 casos, 31.7%), seguido por Mucor sp. (7 casos, 8.53%). Además, se obtuvo un aislado que correspondió a Syncephalastrum sp. y otro a Cunninghamella sp., en 7 casos se desarrollaron hongos filamentosos de micelio cenocítico sin estructuras morfológicas útiles para identificar el género.

Estudio radiológico de paciente con mucormicosis pulmonar que muestra una gran lesión en el lóbulo superior del pulmón derecho y múltiples imágenes radio-opacas diseminadas en ambos campos
Otro caso de infección causada por levaduras fue la criptococosis, que en el periodo estudiado constituyeron el 12.7% (60 casos) del total de las MI. De los 60 aislados de Cryptococcus, 56 correspondieron a C. neoformans, dos a C. laurentii, uno a C. terreus y uno a C. unigutulatus, estas dos últimas especies fueron aisladas en 1995 (figura 3), los pacientes eran del sexo masculino, el factor predisponente fue SIDA y la infección solo se diseminó a sistema nerviosos central.
Colonias de Cryptococcus terreus (Izquierda) y C. laurentii (Derecha). A diferencia de los aislados de C. neoforman, ambas especies forman colonias rugosas, de aspecto seco
Se diagnosticaron 43 casos de aspergilosis, la mayoría de los pacientes estaban internados en los servicios de Hematología, Trasplantes y Cuidados Intensivos. Siete fueron registrados en el año 2009 y coincidieron con la realización de trabajos de remodelación del hospital. En 10 pacientes se identificó Aspergillus fumigatus (23.2%), en 10 A. flavus y en cuatro casos A. niger (9.3%).En 19 aislados solo fue posible determinar el género.
De las micosis endémicas, la más frecuente fue la histoplasmosis (16 casos). Nueve de los pacientes estaban infectados con el VIH; cinco presentaban enfermedades autoinmunes y recibían corticoesteroides de alta potencia y dos pacientes tenían como diagnóstico único síndrome febril en estudio sin factor predisponente conocido. Uno de los pacientes con histoplasmosis, presentó simultáneamente una infección por virus de herpes simple con úlceras cutáneas extensas en nalgas. En el estudio histopatológico de la biopsia de piel, se observaron escasas levaduras, mientras que el cultivo de médula ósea se desarrollaron incontables colonias de Histoplasma capsulatum (figura 4).

Izquierda: Corte histológico de piel donde se observan escasas levaduras de Histoplasma capsulatum en el tejido colágeno. Derecha: cultivo de médula ósea de mismo paciente, donde se observan numerosas colonias del agente
Las micosis invasivas registradas con menor frecuencia fueron coccidioidomicosis, neumocistosis, alternariosis y scedosporiosis. Los cuatro casos de coccidioidomicosis fueron positivos a cultivo y a histopatología; el ED fue positivo en dos casos (uno de pulmón y otro de absceso en mano). Los casos de neumocistosis fueron diagnosticados por inmunofluorescencia directa a partir de LBA; uno de estos pacientes tenía enfermedad de Crohn y además de esteroides habituales en el tratamiento de esa patología, recibió tratamiento con adalimumab. Los dos casos de alternariosis y el caso de scedosporiosis estuvieron localizados en pulmón. El diagnóstico de alternariosis se basó en la observación de hifas pigmentadas en el ED del LBA y el crecimiento de colonias pigmentadas, cuyo examen microscópico mostró los dictioconidios característicos del género. La scedosporiosis fue diagnosticada por la presencia de hifas hialinas en el ED de LBA y por cultivo; microscópicamente este mostró abundantes conidios anelídicos típicos del género.
Discusión
Mundialmente se ha incrementado el número de casos de MI causadas por hongos oportunistas como Candida spp., Cryptococcus spp., Aspergillus spp. y Pneumocystis jirovecii.,4,12-14 sin embargo, en el mundo, no hay datos epidemiológicos precisos de su incidencia o prevalencia global; en México, como ocurre en otros países subdesarrollados, no existen registros sobre la incidencia global de MI, ya que ninguna infección fúngica es de reporte obligatorio.12,14,15
El presente estudio demuestra que este grupo depatologías está subestimado, en México, las MI, nose consideran dentro de las prioridades nacionales desalud. El número de casos registrados en esta casuísticaes elevado, como lo demuestran los 261 casos decandidosis; sin embargo, no correspondan a la realidad,debido a la falta de recursos para realizar técnicasdiagnósticas innovadoras, específicas, sensibles y rápidas. En muchos pacientes en quienes se sospechóalguna MI, el cultivo fue negativo y no se realizaronlas pruebas inmunológicas para confirmar el diagnóstico.Entre las técnicas que han demostrado una buenasensibilidad y especificidad están las de inmunoensayoenzimático (ELISA), útiles para el diagnósticode aspergilosis y candidosis que detectan biomarcadorescomo el 1,3-β-D-glucano o el galactomanano; lainmunofluorescencia directa para la neumocistosis yen la última década, las técnicas moleculares cuya utilidadha sido demostrada en pacientes con candidosisy aspergilosis.5,9,16
En relación a los agentes de candidosis, aunque predominó C. albicans, fue notable el aumento de otras especies como C. tropicalis, C. glabrata y C. parapsilosis que causaron el 18.9% del total de esas infecciones, similar a otros reportes.17 Este cambio de agentes, es importante porque algunas especies como C. glabrata, desarrollan resistencia secundaria con gran facilidad mientras que otras como C. krusei son intrínsecamente resistentes al fluconazol.18,19
En los pacientes que cursaban con mucormicosis rinocerebral, se observó una mortalidad similar a la reportada en la literatura mundial que es cercana al 46 %.20 El pronóstico de la mucormicosis, depende tanto del tratamiento adecuado como de la rapidez con la que los pacientes sean enviados a un centro de atención especializada para tratar las comorbilidades. Sin embargo, a pesar del tratamiento farmacológico, los pacientes generalmente requieren de cirugías extensas en cara, boca, ojos y vías respiratorias superiores, lo que disminuye la calidad de vida en aproximadamente 90 % de los enfermos.
En reportes de la literatura internacional, se refiere que el posaconazol, antimicótico del grupo de los azólicos, es muy efectivo contra estos agentes y poco tóxico para los pacientes, por lo que es una alternativa terapéutica en lugar de la anfotericina B.21,22 Sin embargo, en México la disponibilidad de este azólico es limitada, aún en los hospitales de alta especialidad.
Los casos detectados de criptococosis en este estudio reflejan la tendencia epidemiológica mundial. El número de enfermos se mantuvo elevado hasta 1998, disminuyendo paulatinamente hasta contabilizar solo 10 casos en el periodo de 2009-2013. Esta disminución se debió a un control más adecuado de la infección por VIH mediante la terapia HAART, que fue el principal factor predisponente en estos pacientes.4
Hasta finales del siglo pasado, mundialmente se consideraba que el principal y casi único agente de esta infección era C. neoformans, al que se le reconocían dos variedades: C. neoformans var. neoformans y C. neoformans var. gattii. Estudios morfológicos, fisiológicos y genéticos realizados en ambas variedades, demostraron que son especies diferentes,14 en este estudio no se detectó ningún aislado de C. gattii, pero se identificaron cuatro casos de infección por agentes muy poco reportados como causantes de infección, C. laurentii (dos casos), C. terreus y C. unigutulatus, en todos ellos el factor predisponente fue el SIDA. Estos agentes pueden considerarse como especies emergentes junto con otros como C. liquefaciens y C. albidus que han sido reportados en otros estudios.23,24
La aspergilosis es una patología poco frecuente en la población de este hospital. El incremento de casos observado en 2009 se debió a la realización de trabajos de remodelación en varias áreas del hospital, que como se ha demostrado en otras investigaciones, generan dispersión de conidios, causando infecciones graves en pacientes con inmunosupresión severa.4
En conclusión, este estudio hace patente la urgencia de que todos los hospitales de especialidad que atienden pacientes con inmunosupresión severa de cualquier etiología, dispongan de laboratorios de micología médica con personal capacitado y el material necesario para realizar diagnóstico microbiológico, inmunológico y molecular; así como contar con estudios de sensibilidad antifúngica para indicar el mejor tratamiento. Finalmente, es necesario crear un Centro Nacional de Referencia de Micosis, donde se concentren todos los datos acerca de estas infecciones y contribuya en la elaboración de planes de educación para la salud, prevención, diagnóstico y tratamiento de las micosis.
Referencias
1. Ascioglu S, Rex JH, de Pauw B, Bennett JE, Bille J, Crokaert F, et al. Defining opportunistic invasive fungal infections in immunocompromised patients with cancer and hematopoietic stem cell transplants: an international consensus. Clin Infect Dis 2002;34 (1):7-14.
2. De Pauw B, Walsh TJ, Donnelly JP, Stevens DA, Edwards JE, Calandra T, et al. Revised definitions of invasive fungal disease from the European Organization for Research and Treatment of Cancer/Invasive Fungal Infections Cooperative Group and the National Institute of Allergy and Infectious Diseases Mycoses Study Group (EORTC/MSG) Consensus Group. Clin Infect Dis 2008;46(12):1813-21.
3. Pemán J, Salavert M. Epidemiología general de la enfermedad fúngica invasora. Enferm Infecc Microbiol Clin 2012;30(2):90-8.
4. Pfaller MA, Diekema DJ. Epidemiology of invasive mycoses in North America. Crit Rev Microbiol 2010; 36(1):1-53.
5. Paramythiotou E, Frantzeskaki F, Flevari A, et al. Invasive fungal infections in the ICU: how to approach, how to treat. Molecules 2014;19(1):1085-119.
6. Badiee P, Hashemizadeh Z. Opportunistic invasive fungal infections: diagnosis & clinical management. Indian J Med Res 2014;139(2):195-204.
7. Méndez-Tovar LJ, Manzano-Gayosso P, Cumplido-Uribe Ch, Hernández-Hernández F, Ramos-Hernández J, López-Martínez R. Micosis invasivas en pacientes inmunodeprimidos con fiebre de origen desconocido. Rev Med Inst Mex Seguro Soc 2012; 50(6):609-614.
8. Eggimann P, Bille J, Marchetti O. Diagnosis of invasive candidiasis in the ICU. Ann Intensive Care 2011;1:37
9. Gómez BL. Molecular diagnosis of endemic and invasive mycoses: advances and challenges. Rev Iberoam Micol 2014;31(1):35-41.
10. Álvez F, Figueras C, Roselló E. Infecciones fúngicas invasivas emergentes. Ann Pediatr (Barc) 2010;73 (1):52.e1-e6.
11. Miceli MH, Díaz JA, Lee SA. Emerging opportunistic yeast infections. Lancet Infect Dis 2011;11(2):142-151.
12. Cruz R, Piontelli E. Enfermedad fúngica invasora en pacientes de cinco hospitales de la Región de Valparaíso, Chile. 2004 a 2009. Rev Chil Infect 2011;28 (2):123-129
13. Montagna MT, Caggiano G, Lovero G, De Giglio O, Coretti C, Cuna T, et al. Epidemiology of invasive fungal infections in the intensive care unit: results of a multicenter Italian survey (AURORA Project).Infection 2013;41(3):645-653
14. Sifuentes-Osornio J, Corzo-León DE, Ponce-de-León LA. Epidemiology of Invasive Fungal Infections in Latin America. Curr Fungal Infect Rep 2012; 6(1):23-34.
15. Bitar D, Lortholary O, Le Strat Y, Nicolau J, Coignard B, Tattevin P, et al. Population-based analysis of invasive fungal infections, France, 2001-2010. Emerg Infect Dis 2014;20(7):1149-1155.
16. Quindós G, Eraso E, López-Soria LM, Ezpelata G. Enfermedad fúngica invasora: ¿Diagnóstico micológico convencional o molecular? Enferm Infecc Microbiol Clin 2012;30(9):560-571.
17. Ding X, Yan D, Sun W, Zeng Z, Su R, Su J. Epidemiology and risk factors for nosocomial Non-Candida albicans candidemia in adult patients at a tertiary care hospital in North China. Med Mycol 2015 Jul 30 (Epub ahead of print).
18. Hitchcock CA, Pye GW, Troke PF, Johnson EM, Warnock DW. Fluconazole resistance in Candida glabrata. Antimicrob Agent Chemother 1993;37(9): 1962-1965.
19. Loeffler J, Stevens DA. Antifungal drug resistance. Clin Infect Dis 2003;36 Suppl 1:S31-S41.
20. Roden MM, Zaoutis TE, Buchanan WL, Knudsen TA, Sarkisova TA, Schaufele RL, et al. Epidemiology and outcome of mucormycosis: a review of 929 reported cases. Clin Infect Dis 2005;41(5):634-653.
21. Vehreschild JJ, Birtel A, Vehreschild MJ, Liss B, Farowski F, Kochanek M, et. al. Mucormycosis treated with posaconazole: review of 96 case reports. Crit Rev Microbiol 2013;39(3):310-324.
22. Almannai M, Imran H, Estrada B, Siddiqui AH. Successful treatment of rhino-orbital mucormycosis with posaconazole and hyperbaric oxygen therapy. Pediatr Hematol Oncol 2013;30(3):184-186.
23. Narayan S, Batta K, Colloby P, Tan CY. Cutaneous cryptococcus infection due to C. albidus associated with Sézary syndrome. Br J Dermatol. 2000;143(3): 632-634.
24. Takemura H, Ohno H, Miura I, Takagi T, Ohyanagi T, Kunishima H, et. al. The first reported case of central venous catheter-related fungemia caused by Cryptococcus liquefaciens. J Infect Chemother. 2015;21 (5):392-394.